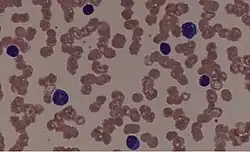

Geldrollenbildung

Mit dem Begriff Geldrollenbildung, Rouleau-Bildung oder Pseudoagglutination (engl. rouleau formation) wird die reversible Bildung von kettenartigen Stapeln roter Blutkörperchen (Erythrozyten) bezeichnet. Rote Blutkörperchen sind deformierbare Körper mit bikonkaver Form von etwa 7 µm Durchmesser, die in diesem Falle aufeinander haften können. Derartige Ketten von roten Blutkörperchen können auch verzweigt sein und in selteneren Fällen Ringe und Schleifen bilden. Zu Beginn der Geldrollenbildung kommt es zur Paarbildung zweier Erythrozyten. Hier wird auch von Kohäsion gesprochen. Eine Geldrollenbildung und der Zerfall wieder zurück in einzelne Erythrozyten kann in wenigen Sekunden erfolgen. Bei einigen Tierarten (beispielsweise bei Pferden) findet sich häufig eine Geldrollenbildung im Blut.
Die Kettenbildungen lassen sich im Lichtmikroskop, Phasenkontrastmikroskop oder mit der Dunkelfeldmikroskopie erkennen.
Entstehung und Bedeutung
Eine geringe Geldrollenbildung ist im menschlichen Körper ein normaler Vorgang, daher werden im geringen Umfang auch derartige Geldrollen roter Blutkörperchen im Blutausstrich des Menschen gefunden. Eine vermehrte Pseudoagglutination findet insbesondere dann statt, wenn die Fließgeschwindigkeit des Blutes abnimmt. Dies ist der Fall in kleinsten Endarterien (Kapillaren) bzw. in den feinen Verästelungen im venösen Schenkel des Blutkreislaufs. Auch nach Einsetzen der Blutgerinnung kann es zur Geldrollenbildung kommen, also im frischen Blut nach Blutentnahme. Dieses Phänomen ist in der Medizin (speziell in der Transfusionsmedizin) schon lange bekannt und hat keinen Krankheitswert. Die Fähigkeit zur Geldrollenbildung ist sogar als ein Anzeichen für „gesundes Blut“, im Sinne eines physiologischen Gerinnungsstatus anzusehen.
Das Aufeinanderhaften der einzelnen roten Blutkörperchen wird bekanntermaßen durch folgende Substanzen oder Zustände gefördert:
- Dysproteinämie (vermehrtes Auftreten hochmolekularer Plasmaproteine (Eiweiße) wie das Fibrinogen)
- Alpha2 Globuline
- Immunglobuline in hoher Konzentration (Paraproteinämie)
- Albumin
- Polylysin
- Dextrane
- hohe Thrombozytenkonzentration
Nach Blutentnahme führt das Eintrocknen von Blut ebenfalls zur Geldrollenbildung und kann bei entsprechenden Tests auch bei gesunden Menschen zu einem positiven Testergebnis führen. Eine Erwärmung von Blutproben erhöht ebenfalls die Wahrscheinlichkeit für dieses Phänomen.
Die Kettenbildung beeinflusst die Blutkörperchensenkungsgeschwindigkeit (BSG) und ist als einer der Mechanismen zur Regelung der Viskosität und thixotropen Eigenschaften des Blutes anzusehen. Nach Ansicht von Fabry (siehe unten) ist die Aggregation Voraussetzung für die Sedimentbildung roter Blutkörperchen. Durch die Kettenbildung wird die Viskosität des Blutes erhöht, und es kann zu einer regelrechten Verstopfung der Kapillaren kommen, eines der Schutzmechanismen vor dem Verbluten. Hier wird dann auch von „Blutschlamm“ gesprochen (engl. sludge). Die Erhöhung der Viskosität ist Ausgangspunkt für einige Verfahren zur quantitativen Bestimmung der Geldrollenbildung. Am verbreitetsten ist die Laser-Reflektometrie. Die Rheoskopie beschreibt unter standardisierten Bedingungen die Geldrollenbildung unter dem Mikroskop in vivo.
Andererseits verringert sich durch das Verkleben der Blutkörperchen die für den Sauerstofftransport verfügbare Blutkörperchen-Gesamtoberfläche. Dies kann zu einer lokalen Verringerung der Sauerstoffversorgung im betroffenen Versorgungsgebiet führen.
Pathologisch vermehrte Geldrollenbildung im Blutbild findet sich bei Thalassämie, multiplem Myelom, Morbus Waldenström, entzündlichen Erkrankungen, Kollagenosen und der Polyglobulie. Auch in der Schwangerschaft kann es zu einer vorübergehenden vermehrten Geldrollenbildung der roten Blutkörperchen kommen. Ferner kommt sie beim Diabetes vor und ist ursächlich für die mikrovaskulären Verschlüsse bei der diabetischen Retinopathie.
Die Geldrollenbildung in der Alternativmedizin
Anders als in der wissenschaftlichen Medizin wird in der Alternativmedizin mancherorts die Ansicht vertreten, dass die Geldrollenbildung als ein obligat pathologisches Geschehen anzusehen sei und die Beobachtung dieses Phänomens sich generell zur Diagnostik einer Reihe von Krankheiten eigne, wobei dabei die Thalassämien und Polyglobulien nicht gemeint sind.
Dabei wird häufig auf eine nicht standardisierte und zumeist unzureichend genau beschriebene, rein qualitative Anwendung der Dunkelfeldmikroskopie zur Beobachtung einer Geldrollenbildung zurückgegriffen. Entsprechende Bluttests sind als Dunkelfeld-Vitalblutdiagnostik bekannt geworden. Ein Nachweis der diagnostischen Spezifität steht noch aus. Die entsprechenden Kosten werden von den Krankenkassen nicht erstattet.
Auf die oben genannten Tests wird zuweilen auch zurückgegriffen, um eine vermeintliche Schädigung des Blutes durch elektromagnetische Felder (EMF) nachzuweisen. Auch hier gibt es keine wissenschaftlichen Untersuchungen, die dokumentiert zeigen würden, dass die rein qualitative Beschreibung einer Geldrollenbildung von roten Blutkörperchen ein Zeichen einer Schädigung des Blutes wäre oder dies in Anwesenheit von EMF überhaupt erst auftreten würde. Da sich im Blutausstrich auch bei völlig gesunden Menschen eine Geldrollenbildung zeigen kann, ist diese Methode nicht aussagekräftig in Bezug auf mögliche Einflüsse elektromagnetischer Felder auf den menschlichen Organismus.
Bei einer netzartig verzweigten Geldrollenbildung wird im alternativmedizinischen Bereich auch von einer „Filitbildung“ gesprochen. Der Begriff Filit geht allerdings auf Ansichten des Zoologen Günther Enderlein zurück, der zu Beginn des 20. Jahrhunderts eine inzwischen widerlegte Theorie zum Pleomorphismus von Mikroben entwickelt hatte.
Ebenso ist die Behauptung, dass eine Übersäuerung des Blutes zu einer „typischen“ Geldrollenbildung führt, wissenschaftlich nicht haltbar. Diese Behauptung findet sich z. B. in bestimmten Ratgebern zur „Entschlackung“.
Literatur
- C. R. Huang: Thixotropic properties of whole blood from healthy human subjects. In: Biorheology. 24(6), 1987, S. 795–801.
- R. W. Samsel, A. S. Perelson: Kinetics of rouleau formation. I. A mass action approach with geometric features. In: Biophysical Journal. Band 37, Nummer 2, Februar 1982, S. 493–514, doi:10.1016/S0006-3495(82)84696-1, PMID 7059652, PMC 1328832 (freier Volltext).
- R. W. Samsel, A. S. Perelson: Kinetics of rouleau formation. II. Reversible reactions. (PDF, 2,64 MB) In: Biophys J. 45(4), Apr 1984, S. 805–824.
- J. F. Stoltz, S. Gaillard, F. Paulus, O. Henri, P. Dixneuf: Experimental approach to rouleau formation. Comparison of three methods. In: Biorheology. Suppl. 1, 1984, S. 221–226.
- T. L. Fabry: Mechanism of erythrocyte aggregation and sedimentation. In: Blood. 70(5), Nov 1987, S. 1572–1576.
Siehe auch
Weblinks
- Frank Gollnick, Gabi Conrad: „Geldrollenbildung“ im Blut verursacht durch Mobilfunk-Felder? ( vom 28. September 2007 im Internet Archive). In: NEWSletter 1/2000, S. 4–7.